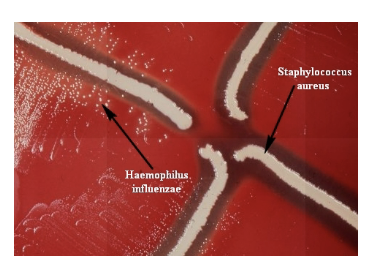

Small Gram Negative Coccobacillus Bordetella and Haemophilus
Bordetella pertissis
minute, encapsulated coccobacillus, strictly aerobic
causes pertussis or whooping cough, a communicable childhood affliction
acute respiratory syndrome
often severe, life-threatening complications in babies
reservoir - apparently healthy carriers
transmission by direct contact or inhalation of aerosols
virulence factors
receptors that recognize and bind to ciliated respiratory epithelial cells- pertactin, filamentous hemagglutinin, fimbria
loss of ciliary mechanism leads to buildup of mucus and blockage of the airway - tracheal cytotoxin
localized tissue destruction: dermonecrotic toxin
toxins that destroy and dislpdge ciliated cells
systemic toxicity: pertussis toxin - inactivates adenylate cyclase- increase in cAMP - increase in respiratory secretions and mucous production, swelling in airways (whopping sound)
adenylate cyclate toxin: blocks phagocytes from migrating to infection site
vaccine - DTaP - acellular vaccine contains toxoid and other Ags
Whooping Cough
incubation period: 7-10 dats
3 stages of the disease: catarrhal stage (resembles the common cold; lasts for 2 weeks), progressing to the paraxysmal stage (repetitive coughs followed by inspiratory whoops - pertussis toxin; lasts 1-6 weeks), then the convalescence stage (diminishing paroxysms and secondary complication (pneumonia, seizures and encephalopathy; lasts 2-3 weeks)
Diagnosis
culture swab taken from nasopharynx
identification of bacteria by polymerase chain reaction
direct fluorescent antibody
serology: antibody response
Vaccine
DTAP vaccine: diphtheria, tetanusm pertussis
> 90% effective
needs boosters in elderly
Haemophilus: General Characteristics
small gram negative coccobacilli
facultative anaerobic
3 species of medical importance:
H. influenza
H. ducreyi
H. aegyptius
Haemophilus influenzae
small gram negatuve coccobacillus
facultative anaerobic
lives in mucous membranes of humans
nonencapsulated (40-80% children and adults); capsulated (3-5 children)
a fastidious organism, H.influenzae will only grow on media with available factor X (hemin) and factor V (vitamin-NAD), like chocolate agar
satellite testing for H. influenzae: grows in the hemolysis zone with S. aureus
Virulence Factors
capsulated strains: six serotypes - type B causes 95% of infections
polysaccharide capsule: antiphagocytic
attach to epithelial cells in airways
pili and adhesion proteins (HMW1 and HMW2)
lipooligosacchardies (LOS) in outer membrane: inhibits the self cleaning mechanism- mucociliary clearance
IgA protease
causes invasive infections
vaccine for b serotype
unencapsulated strains - untypeable
attach to epithelial cells in airways
lipooligosaccharides (LOS) in outer membrane: each time they infect a cell
phase variation
IgA protease
biofilms
cause infection of mucosal surfaces by direct extension
otitis media
sinusitis
bronchitis
H. influenzae: infection
risk factors for Type B:
children
splenectomy
malignancies
deficiency in complement proteins
acute viral infection: influenza virus
risk factors for nontypable:
children
immunocompromised
acute viral infection: influenza virus
underlying lung condition

Haemophilus influenzae
epiglotitis
fever
sorethroat
difficulty speaking
meningitis
occurs mostly in children (6 months to 4 years)
fever, lethargy
vomiting
soreneck
altered mental status
Haemophilus influenzae Pneumonia
nontypable stain major concern
symptoms: fever, chills. chest pain. cough, shortness of breath
diagnosis: isolation; special media for nutritional requirements
treatment: cephalosporins - growing beta lactam resistance
Haemophilus influenzae Vaccine
the Hib conjugate vaccien is an inactivated vaccine
it is made by chemically bonding to a polysacchardie (sugar) to diphtheria toxoid
this long chain of sugar molecules makes up the surface capsule of the bacterium.
since the vaccine, cases of this type of meningitis have been decreasing

Chancroid
caused by gram0negative coccobacillus
Haemophilus ducreyi
obligate human pathogen
soft chancres on the genitals or other areas associated with sexual contact
painful, open sores that may bleed or produce fluid that is highly contagious
sexually transmitted
antibiotic treatment


Bacterial Conjuctivitis: H. aegyptius
